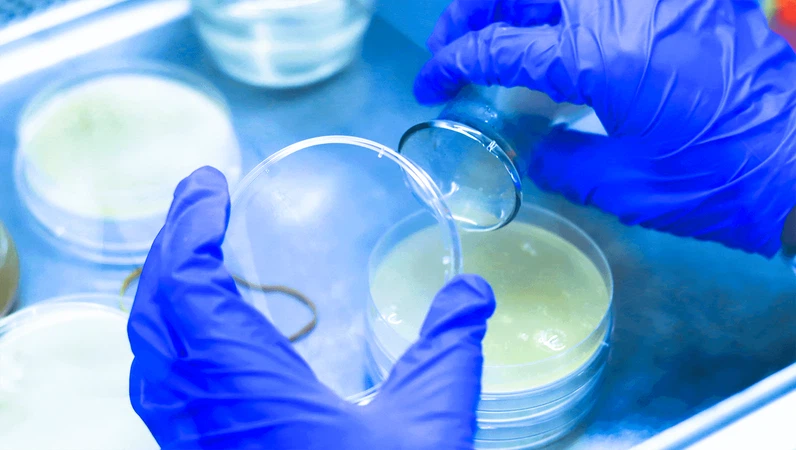
product-1600-905 product-1600-905

Introducción del producto
L-lisina HCL en polvoes una forma del aminoácido esencial L-lisina que se ha procesado en forma de polvo. La lisina es un aminoácido que el cuerpo no puede producir por sí solo y debe obtenerse a través de la dieta o la suplementación. Desempeña varias funciones importantes en el cuerpo, incluida la síntesis de proteínas, la formación de colágeno, la producción de enzimas y el apoyo al sistema inmunológico.
Se utiliza comúnmente como suplemento dietético debido a sus posibles beneficios para la salud. El polvo se toma a menudo como suplemento dietético para garantizar una ingesta adecuada de lisina, especialmente en personas con dietas deficientes en lisina o necesidades de salud específicas.
La L-lisina participa en la producción de anticuerpos, enzimas y hormonas que desempeñan un papel vital en el apoyo al sistema inmunológico. Puede ayudar a mejorar la función inmune y brindar apoyo en momentos de mayor estrés o enfermedad.
La lisina es un componente esencial en la síntesis de colágeno. El colágeno es una proteína crucial que proporciona soporte estructural a varios tejidos del cuerpo, incluidos la piel, los huesos y los tejidos conectivos. El polvo puede ayudar en la producción de colágeno y promover la reparación saludable de la piel y los tejidos. Se puede consumir mezclándolo con agua, jugo u otras bebidas.

Especificación del producto

Conclusión: Cumple con el estándar USP36.
Vida útil: 24 meses en el envase original sin abrir
Embalaje y almacenamiento: Embalado en bolsas de 25 kg. Se almacenará a temperatura ambiente, en condiciones secas, protegido del calor, la luz, el oxígeno y la humedad.

Aplicación del producto
L-lisina HCL en polvoTiene diversas aplicaciones debido a sus potenciales beneficios para la salud y funciones en el cuerpo. A continuación se muestran algunas aplicaciones comunes:
- Suplemento dietético: a menudo se toma como suplemento dietético para garantizar una ingesta adecuada de lisina, especialmente en personas con dietas deficientes en lisina o afecciones médicas específicas que requieren una mayor ingesta de lisina.
- Prevención y tratamiento del herpes labial: se utiliza popularmente para prevenir y controlar el herpes labial causado por el virus del herpes simple (VHS). Puede ayudar a inhibir la replicación viral y reducir la frecuencia y duración de los brotes de herpes labial.
- Salud de la piel: puede ayudar en la producción de colágeno, que es una proteína crucial que proporciona soporte estructural a varios tejidos del cuerpo, incluida la piel. Puede promover la reparación saludable de la piel y los tejidos.
- Rendimiento atlético y recuperación muscular: algunos atletas y culturistas utilizan este polvo como suplemento dietético para apoyar el crecimiento muscular, la recuperación y el rendimiento del ejercicio. Puede ayudar en la síntesis de proteínas y contribuir a la salud muscular.
- Apoyo inmunológico: La L-lisina participa en la producción de anticuerpos, enzimas y hormonas que desempeñan un papel vital en el apoyo al sistema inmunológico. Puede ayudar a mejorar la función inmune y brindar apoyo en momentos de mayor estrés o enfermedad.
- Alimentación para animales:L-lisina HCL en polvoSe utiliza comúnmente en la alimentación animal para garantizar una ingesta adecuada de lisina y promover el crecimiento y el desarrollo.

Embalaje y almacenamiento
Embalado en sacos de 25 kg. Se almacenará a temperatura ambiente, en condiciones secas y protegido del calor, la luz, el oxígeno y la humedad.

Vista de fábrica (haga clic para obtener detalles del video)
 |
|
 |
 |
|
 |
|
|
 |
Etiqueta: l-lisina hcl en polvo, China, fábrica, fabricantes, proveedor, productor, venta al por mayor, compra, precio, a granel, mejor, en venta























